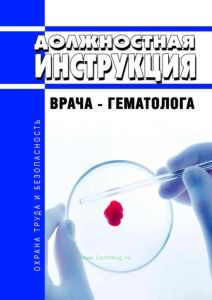
Должностная инструкция врача-гематолога

Нормативные документы регламентируют ведение тех, или иных учетных форм (журналов, актов, нарядов и т.д.). В случае, когда приказ утрачивает силу, автоматически считаются отмененными (недействующими) и формы, введенные этим документом.
Если взамен приказа вводится новый, мы стараемся это указывать и давать ссылки.
Бывает так, что в действующем приказе не приводится форма журнала. В таких случаях Правительство возлагает разработку учетного документа на руководителя предприятия.
Пример №1
Постановлением Минтруда РФ от 10.10.2003 N 69 была введена форма Книги учета движения трудовых книжек и вкладышей в них. 31.08.2021 данное постановление утратило силу в связи с выходом Приказа Минтруда России от 19.05.2021 N 320н. Соответственно, книга учета, введенная старым Постановлением, утратила силу. Новый Приказ гласит: «Работодатель самостоятельно разрабатывает книги (журналы) по учету бланков трудовой книжки и вкладыша в нее и учета движения трудовых книжек». Для облегчения работы наших клиентов специалисты типографии «ЦентрМаг» разработали форму Книги учета движения трудовых книжек и вкладышей в них согласно действующему законодательству по состоянию на 01.09.2021. Она носит рекомендательный характер, пользоваться данной формой, или нет, каждый принимает решение самостоятельно.
Пример №2
Распоряжением Росавтодора от 23.05.2002 N ИС-478-р ввели в действие большое количество учетных форм, в том числе Журнал подводного бетонирования (Форма Ф-49). Распоряжением Минтранса России от 11.12.2017 N МС-226-р данный документ, а значит и все журналы, приведенные в нем, также утратили силу. В связи с тем, что на законодательном уровне не было введено нового Приказа, регламентирующего ведение производственно-технической документации при строительстве (реконструкции) автомобильных дорог и искусственных сооружений на них, многие организации продолжают заказывать и пользоваться фактически отмененными формами.
Допустимо это, или нет, следует узнавать у контролирующих организаций.